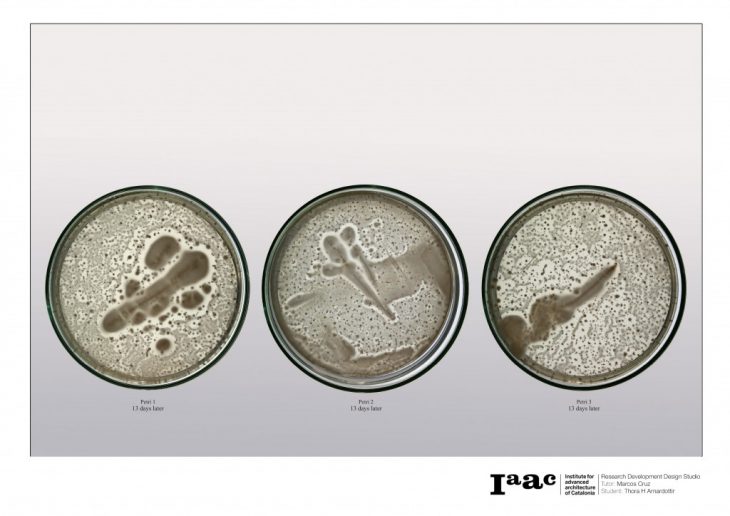

MICROBIAL SCAFFOLDING
study of ureolytic bacterial calcium carbonate precipitation

Microorganisms involvement in the process of carbonate precipitation in biomineralization, can offer a new approach to the anatomy of structures by the deposition of this hard calcareous material. By studying this formation of mineral scaffolding, building design could be able to respond to its environment and grow materials that can reduce CO2 emission and require less energy to produce. Compared to traditional construction materials.

MICROBIAL SCAFFOLDING is a project of IaaC, Institute for Advanced Architecture of Catalonia developed at Master in Advanced Architecture, MAA02 in 2016/17 by:
Student:
Thora H Arnardottir (website)
Tutor: Marcos Cruz
Assistant: Nina Jotanovic
?
Biology Support: Nuria Conde Pueyo
Computational Support: Rodrigo Aguirre & Angelos Chronis
Fabrication Support: Kunal Chadha